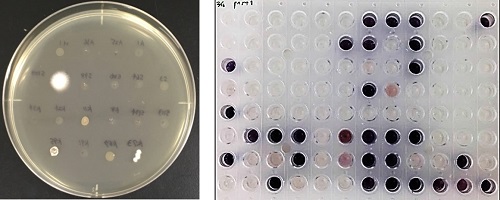

本学の注目研究を毎月1つずつ紹介します。
※最新の注目研究や他のバックナンバーはこちら
森林破壊、大気汚染、海洋汚染、地球温暖化など、様々な環境問題が深刻化しています。そのため、地球規模で環境を改善するための取り組みが急務となっています。海洋汚染は、海洋プラスチックごみや原油流出、工業・生活排水による汚染などにより引き起こされています。特に、海洋プラスチックごみの量は増え続けており、2050年までに海のプラスチックごみの量は全ての魚の量を超えるとされています。海洋プラスチックごみは海洋生物に影響を及ぼすだけでなく、マイクロプラスチックを通して私たちの健康にも被害を及ぼすとされています。また、地球温暖化は、二酸化炭素やメタンなどの温室効果ガスにより地球全体の気温が上昇する現象です。地球温暖化により、気候変動がもたらされ異常気象や干ばつなどが頻発するとされています。その結果、海面上昇による陸地面積の減少や食糧不足が起こると考えられています。
海洋プラスチックごみや地球温暖化の問題を解決する手段の一つとして、バイオプラスチック(生分解性プラスチックとバイオマスプラスチック)の利用が考えられます。生分解性プラスチックは、環境中に廃棄されても速やかに環境微生物により分解されるため、マイクロプラスチックとして残留しにくいとされています。また、バイオマスプラスチックは、植物などの生物資源から作られるプラスチックです。そのため、大気中への二酸化炭素排出量を変化させない性質(カーボンニュートラル)を持つので、地球温暖化を抑制する効果があるとされています。
バイオマスプラスチックの原料は微生物を用いて植物などの生物資源を発酵することで得られます。微生物の機能を開拓し利用することで、新しい構造や機能を持つバイオプラスチックの開発へと繋げることができます。私の研究室では、バイオプラスチックの開発を通して、環境問題の解決を図り持続可能な社会の実現を目指しています(専攻HP https://www.biobased.kit.ac.jp/)。

土の中には無数の微生物が存在します。その多くは機能未知であり、新しいバイオマスプラスチック原料を生産するものも存在していると考えられます。アクリル酸は重合反応性が良く、プラスチック原料として広く利用されています。しかし、アクリル酸は生物毒性が高いで微生物に作らせるのは困難です。一方、アクリル酸の分子骨格を持ったイタコン酸は、微生物で生産できるので汎用的なプラスチック原料としての利用が模索されています。
私の研究室では、イタコン酸を生産する微生物を効率的に土壌から探し出すための技術を開発しました。イタコン酸の末端二重結合の構造に注目し、この末端二重結合への特異的な付加反応である「チオール・エン反応」と「溝呂木・ヘック反応」を微生物の分離に応用しました。DISCOVERと命名した本技術では、まず、分離源である土壌をチオグリセロール入り寒天培地に塗布しイタコン酸生産菌をコロニーとして優先的に増殖させます。次に、分離した微生物の培養液をヨードベンゼンと反応させ呈色を調べることで、分離した微生物が作るイタコン酸の量を迅速に分析します。本技術は、簡便にイタコン酸生産菌を分離できる点で優れます。また、微生物の分離に上述の有機合成反応を利用した初めての試みです。

DISCOVERを用いて日本各地の土壌からイタコン酸生産菌を探索しました。その過程で、イタコン酸とは異なる構造を持つイタコン酸類縁体である9-ヒドロキシヘキシルイタコン酸(9-HHIA)と10-ヒドロキシヘキシルイタコン酸(10-HHIA)を生産する新規微生物であるAspergillus niger S17-5を発見しました。本菌をジャー培養して得られた培養液から10-HHIAを精製後、水中でラジカル重合によりイタコン酸と共重合させることで、新しいバイオプラスチックであるポリ(10-HHIA -co-イタコン酸)を合成することに成功しました。本成果は、微生物が生産するイタコン酸類縁体をバイオマスプラスチック原料として使用した初めての例です。



自然界いる微生物をそのまま利用するだけでは発酵生産できるバイオマスプラスチック原料の種類や量は限られてしまいます。そこで、遺伝子を人工的に操作した微生物を用いることで、本来生産できないプラスチック原料を作らせたり生産量を高めたりすることができます。これまでに私の研究室では、イタコン酸やプロピレングリコールなどの様々なバイオマスプラスチック原料を効率よく作る遺伝子組み換え微生物の開発を行ってきました。ここでは、プロピレングリコールを生産する微生物の開発について紹介します。

大腸菌の遺伝子を操作してプロピレングリコールを発酵生産できるようにしました。具体的には、異なる生物由来のプロピオン酸CoAトランスフェラーゼ、アルデヒドデヒドロゲナーゼ、ラクトアルデヒドレダクターゼをコードする各遺伝子を大腸菌に導入し、グルコースを炭素源として乳酸を経てプロピレングリコールを生産するための代謝経路を作出しました。その結果、開発した遺伝子組み換え大腸菌を96時間培養することで13 mg/Lのプロピレングリコールが得られました。大腸菌ではプロピレングリコールの前駆物質である乳酸の生産性があまり高くありません。そこで、プロピレングリコールの生産性を高めるために、乳酸を多量に生産する乳酸菌を用いて同様の方法で発酵生産を試みました。マンニトールとグルコン酸を炭素源として遺伝子組み換え乳酸菌を培養した結果、生産性は140倍以上も向上し、1.88 g/Lのプロピレングリコールを生産することができました。このように、代謝経路を改変する技術(代謝工学)と培養の最適化(培養工学)を組み合わせることで、本来生産できないバイオマスプラスチック原料を効率よく微生物に作らせることができます。


2015年に国連持続可能な開発サミットが開催され、2030年までに持続可能な社会を構築することを目指して、「我々の世界を変革する:持続可能な開発のための2030アジェンダ」が採択されました。その行動計画として、17の目標からなる「SDGs(Sustainable Development Goals、持続可能な開発目標)」が掲げられました。SDGsのうち環境問題の解決を目指す目標としては、「13.気候変動に具体的な対策を」、「14.海の豊かさを守ろう」、「15.陸の豊かさも守ろう」があります。将来に向けて全人類が力を合わせてSDGsを実現することで環境問題を解決し、住みよい地球環境づくりを目指す姿勢が求められています。SDGsの実現に向けてバイオマスプラスチックの開発が世界中で進められています。
バイオマスプラスチックが広く世の中に普及するためには、安価で従来のプラスチックよりも高性能である必要があります。また、上市されているバイオマスプラスチックの種類はまだ少ないので、その種類を増やし新たな用途展開を図ることも重要です。私の研究室では、微生物の探索と機能改良を通じて、新しいバイオマスプラスチック原料を開拓しバイオマスプラスチックの普及を図ることで、SDGsの実現を目指していきます。
※最新の注目研究や他のバックナンバーはこちら